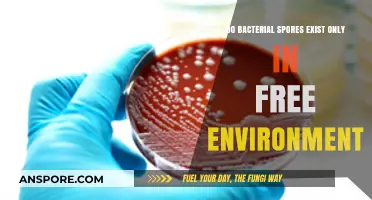
Bacterial Spores: Free Environment Exclusive or Hidden in Hosts?

Angiosperms, commonly known as flowering plants, are the most diverse group of land plants and play a crucial role in ecosystems worldwide. Unlike ferns, mosses, and fungi, which reproduce via spores, angiosperms have evolved a more complex reproductive strategy centered around seeds. Their reproduction involves the production of flowers, which contain reproductive structures such as stamens (male) and pistils (female). Pollination, often facilitated by insects, birds, or wind, transfers pollen from the stamen to the pistil, leading to fertilization and the development of seeds within fruits. This seed-based reproduction ensures genetic diversity and allows angiosperms to thrive in various environments, making them distinct from spore-reproducing organisms.
| Characteristics | Values |
|---|---|
| Reproduction Method | Angiosperms do not reproduce by spores. They reproduce sexually through seeds. |
| Reproductive Structures | Flowers, which contain male (stamens) and female (pistils) reproductive organs. |
| Pollination | Typically involves external agents like insects, wind, or water. |
| Fertilization | Double fertilization: one sperm fertilizes the egg to form the zygote, and another fuses with polar nuclei to form the endosperm. |
| Seed Formation | Ovules develop into seeds after fertilization, containing an embryo, endosperm, and seed coat. |
| Dispersal | Seeds are dispersed by various means (wind, animals, water) to ensure species survival. |
| Life Cycle | Alternation of generations with a dominant sporophyte phase (plant body) and a reduced gametophyte phase (pollen and embryo sac). |
| Spores in Life Cycle | Spores are produced in the reduced gametophyte phase (e.g., pollen grains) but are not the primary means of reproduction. |
| Comparison to Spores | Unlike spore-producing plants (e.g., ferns, mosses), angiosperms rely on seeds for reproduction and dispersal. |
Explore related products
$13.99 $17.99
What You'll Learn
- Angiosperm Life Cycle Overview: Angiosperms follow alternation of generations, but spores are not part of their reproductive process
- Flower Structure Role: Flowers facilitate sexual reproduction via seeds, not spore production, in angiosperms
- Seed Formation Process: Angiosperms produce seeds through double fertilization, bypassing spore-based reproduction entirely
- Comparison with Ferns: Unlike ferns, angiosperms do not rely on spores for reproduction or dispersal
- Spore Reproduction in Plants: Spores are used by non-seed plants like ferns, not angiosperms, for asexual reproduction

Angiosperm Life Cycle Overview: Angiosperms follow alternation of generations, but spores are not part of their reproductive process
Angiosperms, commonly known as flowering plants, are the most diverse group of land plants, yet their reproductive strategy often leads to misconceptions. Unlike ferns or mosses, angiosperms do not produce spores as part of their life cycle. Instead, they rely on seeds for reproduction, a trait that has contributed to their evolutionary success. This distinction is crucial for understanding how angiosperms thrive in various ecosystems, from tropical rainforests to arid deserts.
The life cycle of angiosperms is characterized by alternation of generations, a phenomenon where the plant alternates between a diploid sporophyte phase and a haploid gametophyte phase. However, the gametophyte in angiosperms is highly reduced and dependent on the sporophyte. For instance, the male gametophyte is the pollen grain, and the female gametophyte is the embryo sac, both of which are microscopic and short-lived. This reduction in the gametophyte phase is a key adaptation that allows angiosperms to invest more energy in seed and flower production rather than spore dispersal.
To illustrate, consider the process of double fertilization in angiosperms, a unique mechanism where two sperm cells from the pollen fertilize the egg and central cell of the embryo sac. This results in the formation of the zygote, which develops into the embryo, and the endosperm, a nutrient-rich tissue that supports seedling growth. This complex process highlights the sophistication of angiosperm reproduction, which bypasses the need for free-living gametophytes or spore-mediated dispersal.
From a practical standpoint, understanding that angiosperms do not reproduce via spores has implications for horticulture and agriculture. Gardeners and farmers focus on seed viability, pollination, and fruit development rather than spore germination. For example, techniques like hand-pollination in greenhouses or seed treatment with fungicides are tailored to the angiosperm life cycle. This knowledge ensures higher yields and healthier plants, demonstrating the applied value of recognizing angiosperms' unique reproductive strategy.
In conclusion, while angiosperms exhibit alternation of generations, their reproductive process is distinctly seed-based, not spore-based. This adaptation has allowed them to dominate terrestrial ecosystems and become the foundation of global agriculture. By focusing on seeds and flowers, angiosperms have evolved a reproductive strategy that maximizes efficiency and success, setting them apart from spore-producing plants. This understanding is essential for both scientific study and practical applications in plant cultivation.
Mold Spores: Are They Truly Everywhere in Our Environment?
You may want to see also

Flower Structure Role: Flowers facilitate sexual reproduction via seeds, not spore production, in angiosperms
Angiosperms, commonly known as flowering plants, are distinct in their reproductive strategy. Unlike ferns and mosses, which rely on spores for reproduction, angiosperms produce seeds as the primary means of propagating their species. This fundamental difference is rooted in the structure and function of flowers, which serve as the reproductive organs of angiosperms. Flowers are not merely decorative; they are highly specialized structures designed to facilitate sexual reproduction through the fusion of male and female gametes, ultimately resulting in seed formation.
Consider the anatomy of a flower: it consists of male (stamens) and female (pistils) reproductive parts, surrounded by petals and sepals. The stamens produce pollen, which contains the male gametes, while the pistil houses the ovules, each containing a female gamete. Pollination, often mediated by insects, birds, or wind, transfers pollen from the stamens to the stigma of the pistil. This process initiates fertilization, where male and female gametes combine, leading to the development of a seed within the ovary. The ovary, in turn, matures into a fruit, which protects the seed and aids in its dispersal. This intricate sequence underscores the flower’s role in ensuring sexual reproduction and seed production, rather than spore-based reproduction.
To illustrate, compare the life cycle of a fern to that of an angiosperm like an apple tree. Ferns release spores that grow into gametophytes, which produce gametes for sexual reproduction. In contrast, an apple tree’s flowers undergo double fertilization: one sperm fertilizes the egg to form the embryo, while the other fuses with the polar nuclei to create endosperm, a nutrient-rich tissue that nourishes the developing seed. This process, unique to angiosperms, highlights the flower’s central role in seed formation, bypassing the need for spores entirely.
Practical observations can reinforce this understanding. For instance, gardeners can dissect a flower to identify its reproductive parts and observe how pollination leads to fruit and seed development. A simple experiment involves hand-pollinating a flower (e.g., a squash blossom) and comparing it to an unpollinated one. The pollinated flower will develop into a fruit containing seeds, while the unpollinated flower will wither. This hands-on approach demonstrates the flower’s indispensable role in sexual reproduction and seed production, dispelling any notion of spore involvement in angiosperms.
In conclusion, the flower’s structure and function are finely tuned to support sexual reproduction via seeds, not spores. By understanding the mechanics of pollination, fertilization, and seed development, one can appreciate the elegance of angiosperm reproduction. This knowledge not only clarifies the distinction between spore- and seed-based reproduction but also emphasizes the flower’s pivotal role in the life cycle of flowering plants. Whether in a classroom, garden, or natural setting, this insight offers a deeper appreciation for the complexity and beauty of angiosperms.
Can You Play Spore Offline? Exploring the Game's Offline Mode
You may want to see also

Seed Formation Process: Angiosperms produce seeds through double fertilization, bypassing spore-based reproduction entirely
Angiosperms, or flowering plants, stand apart in the plant kingdom due to their unique reproductive strategy. Unlike ferns, mosses, and fungi, which rely on spores for reproduction, angiosperms bypass this method entirely. Instead, they employ a sophisticated process called double fertilization, a cornerstone of their seed formation. This mechanism not only ensures genetic diversity but also encapsulates the embryo within a protective seed, fostering survival and dispersal.
Double fertilization begins with the transfer of pollen from the anther to the stigma, a process often facilitated by wind, water, or animals. Once the pollen grain germinates, it produces a pollen tube that grows down the style toward the ovary. Inside the ovary, two sperm cells are delivered: one fuses with the egg cell to form the zygote, the future embryo, while the other combines with the central cell to create the endosperm, a nutrient-rich tissue that sustains the developing embryo. This dual fusion is the hallmark of angiosperm reproduction, setting the stage for seed development.
The ovary, now fertilized, undergoes transformations to become the fruit, while the ovule matures into the seed. Within the seed, the embryo develops, surrounded by stored nutrients and a protective seed coat. This structure ensures the embryo’s survival during dormancy and provides energy for germination. For example, in a sunflower, the endosperm stores oils and proteins, which fuel the seedling’s growth until it can photosynthesize independently. This efficient packaging of life is a testament to the evolutionary success of angiosperms.
Practical considerations for gardeners and botanists include understanding the timing of fertilization and seed development. For instance, hand-pollination in greenhouses requires precise timing to ensure pollen viability and receptive stigmas. Additionally, knowing the specific nutrient requirements of the endosperm can optimize seed health. For crops like wheat or rice, where the endosperm is the harvested product, managing soil fertility and water availability during fertilization is critical. This knowledge bridges the gap between theoretical biology and applied horticulture.
In contrast to spore-based reproduction, which relies on environmental conditions for dispersal and germination, angiosperm seeds are self-contained units of potential life. This adaptation allows angiosperms to colonize diverse habitats, from arid deserts to lush rainforests. By eliminating the need for spores, angiosperms have evolved a reproductive strategy that maximizes efficiency and resilience. Whether in a backyard garden or a vast agricultural field, the seed formation process in angiosperms remains a marvel of biological engineering, ensuring the continuity of life in a changing world.
Freezing Mushroom Spores: Preservation Techniques and Long-Term Storage Tips
You may want to see also
Explore related products

Comparison with Ferns: Unlike ferns, angiosperms do not rely on spores for reproduction or dispersal
Angiosperms, or flowering plants, stand apart from ferns in their reproductive strategies. While ferns depend on spores for both reproduction and dispersal, angiosperms utilize seeds as their primary means of propagation. This fundamental difference shapes their life cycles, ecological roles, and evolutionary success. Ferns release spores that develop into gametophytes, which then produce eggs and sperm. In contrast, angiosperms produce flowers that facilitate pollination, leading to the formation of seeds containing embryonic plants. This seed-based approach provides angiosperms with greater adaptability and resilience in diverse environments.
Consider the practical implications of these reproductive methods. Fern spores are lightweight and easily dispersed by wind, allowing them to colonize new areas quickly. However, they require specific conditions—moisture and shade—to germinate and grow. Angiosperms, on the other hand, package their offspring in protective seeds, which can withstand harsh conditions such as drought or cold. This adaptability explains why angiosperms dominate most terrestrial ecosystems, from deserts to rainforests. For gardeners, understanding this difference is crucial: ferns thrive in humid, shaded areas, while angiosperms can be cultivated in a wider range of settings.
From an evolutionary perspective, the shift from spore-based to seed-based reproduction marks a significant advancement. Seeds provide a built-in food source for the developing embryo, increasing the chances of survival. Additionally, angiosperms have co-evolved with pollinators like bees and butterflies, ensuring efficient reproduction. Ferns, while successful in their own right, lack this level of sophistication. For educators, highlighting this comparison can illustrate the principles of natural selection and adaptation in plant biology.
Finally, the distinction between ferns and angiosperms offers practical tips for conservation efforts. Ferns are often indicators of undisturbed, moist habitats, making them valuable in ecological assessments. Angiosperms, with their diverse forms and functions, play critical roles in carbon sequestration, soil stabilization, and food production. By understanding their reproductive differences, conservationists can tailor strategies to protect both groups. For instance, preserving fern habitats might involve maintaining shade and moisture, while angiosperm conservation could focus on pollinator-friendly practices and seed banking. This knowledge bridges the gap between scientific theory and real-world application.
Can Alcohol Effectively Eliminate Mold Spores? Facts and Myths Revealed
You may want to see also

Spore Reproduction in Plants: Spores are used by non-seed plants like ferns, not angiosperms, for asexual reproduction
Plants employ diverse reproductive strategies, but not all rely on seeds. Non-seed plants, such as ferns, mosses, and liverworts, utilize spores for asexual reproduction. These microscopic, single-celled structures are produced in vast quantities and dispersed by wind or water, allowing the plant to colonize new areas. Spores are lightweight and resilient, capable of surviving harsh conditions until they find a suitable environment to germinate. This method contrasts sharply with the reproductive mechanisms of angiosperms, which depend on seeds for propagation.
Understanding spore reproduction requires a closer look at the life cycle of non-seed plants. Ferns, for instance, exhibit an alternation of generations, cycling between a sporophyte (spore-producing) and a gametophyte (gamete-producing) phase. The sporophyte releases spores that develop into gametophytes, which in turn produce eggs and sperm. Fertilization occurs when sperm swim to the egg, forming a new sporophyte. This process is entirely asexual until fertilization, highlighting the role of spores as a means of dispersal rather than a direct method of sexual reproduction.
In contrast, angiosperms (flowering plants) reproduce via seeds, which contain an embryo, stored food, and a protective coat. Seeds develop from the ovule after fertilization, a process involving pollen transfer from the male reproductive structure to the female structure. This method ensures genetic diversity through sexual reproduction and provides the embryo with resources for initial growth. While spores are efficient for asexual reproduction in non-seed plants, angiosperms have evolved a more complex system that combines sexual reproduction with the advantages of seed dispersal and protection.
Practical observations of spore reproduction can be made by examining ferns in their natural habitat. Look for the undersides of fern fronds, where spore cases (sporangia) are often clustered in patterns called sori. These structures release spores when mature, which can be collected and observed under a microscope. For educational purposes, spores can be sown on a damp, sterile medium to observe gametophyte development. This hands-on approach illustrates the asexual nature of spore reproduction and its role in the plant’s life cycle, distinct from the seed-based reproduction of angiosperms.
In summary, spore reproduction is a specialized strategy employed by non-seed plants like ferns, enabling asexual dispersal and colonization. Angiosperms, however, rely on seeds for reproduction, combining sexual diversity with protective and nutritional advantages. Recognizing these differences clarifies why angiosperms do not reproduce by spores, emphasizing the unique adaptations of each group to their respective environments.
Ordering Spores and PF Tek: Legal Risks and Consequences Explained
You may want to see also
Frequently asked questions
No, angiosperms (flowering plants) reproduce primarily through seeds, not spores.
Angiosperms reproduce sexually through the production of flowers, which develop into fruits containing seeds.
While angiosperms do not reproduce via spores, they produce spores during their alternation of generations, specifically in the formation of gametophytes (pollen and embryo sacs).
Angiosperms rely on seeds for reproduction, which are protected and contain stored nutrients, whereas spore-reproducing plants like ferns release spores that develop into independent gametophytes.